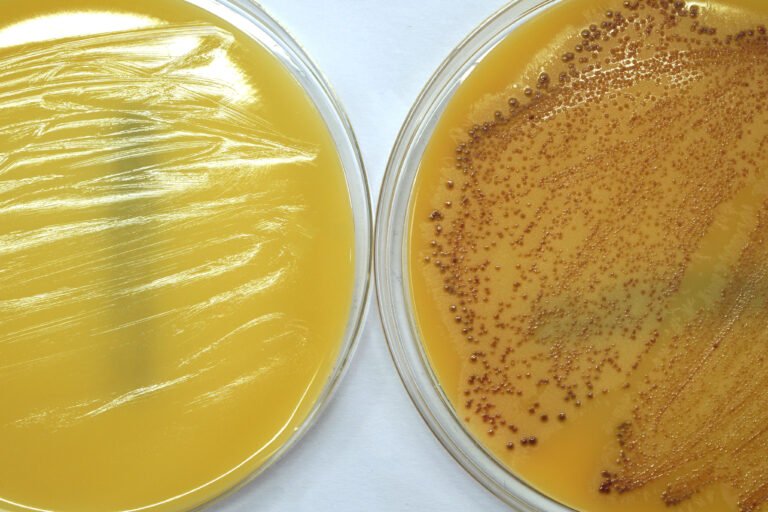

Resistência Antimicrobiana
A chamada financiou 11 projetos para desenvolver soluções inovadoras para combater a resistência antimicrobiana.
Desafio
O uso adequado de antibióticos tem o poder de salvar vidas nas comunidades mais vulneráveis e a resistência aos antimicrobianos (RAM) gera diversos impactos em áreas prioritárias para a saúde pública como: HIV/AIDS, tuberculose, saúde materno-infantil, pneumonia e doenças entéricas e diarreicas.
Portanto, é fundamental entender melhor a prevalência de RAM e seus impactos na mortalidade em países em desenvolvimento para limitar o uso incorreto de antibióticos e garantir o acesso aos antibióticos adequados em caso de resistência. É necessário entender melhor a resistência em casos de infecções bacterianas em recém-nascidos e crianças – e, nesse sentido, conhecer a prevalência da RAM nestas comunidades – e o impacto na mortalidade e nas metas de saúde para este público. Enfrentar a RAM exige chegar a novas perspectivas e soluções para o problema sendo necessária uma abordagem coordenada e global e a união de pesquisadores de diferentes áreas.
Objetivo
O programa buscou financiar novas abordagens com potencial de transformar iniciativas em saúde pública em ações de impacto em escala regional e global por meio da identificação e preenchimento de lacunas de conhecimento sobre a incidência da resistência a agentes antibacterianos.
Especificamente foram financiados projetos inovadores nas seguintes áreas:
- novas fontes de dados, particularmente aquelas que atrairão a atenção de diferentes comunidades de pesquisa de diversas disciplinas para a busca de novas perspectivas para a solução do problema;
- protótipos de abordagens de bioinformática, incluindo novas formas de analisar, combinar e conectar bancos de dados já existentes para gerar conclusões sobre a prevalência de RAM;
- protótipos de novos de biomarcadores ou combinações de biomarcadores que possam levar a uma nova compreensão das implicações práticas dos dados de vigilância sobre resistência aos antimicrobianos;
- projetos experimentais para o desenvolvimento de novas tecnologias e produtos, incluindo:
- aqueles que foquem especificamente em melhorar o controle e a prevenção de infecções em estabelecimentos de saúde para reduzir a dependência da mudança de comportamento de agentes de saúde e
- tecnologias para remover antibióticos de efluentes.
Projetos em Resistência Antimicrobiana

Utilização de aptâmeros de DNA de baixo custo imobilizados em filtro de celulose para remover resíduos de antibióticos em efluentes

Dinâmica da circulação de microrganismos resistentes aos antimicrobianos entre ambientes hospitalares e de criação animal

OneBR (One Health Brazilian Resistance): Base Genômica Integrada para Vigilância, Diagnóstico, Gerenciamento e Tratamento da Resistência Antimicrobiana na Interface Humana-Animal-Ambiental

SMART-CDSS - Um Sistema de Inteligência Artificial para fortalecer a prescrição de antimicrobianos

Monitoramento da resistência aos antimicrobianos em uropatógenos de pessoas da comunidade e sua correlação genética com determinantes de resistência isolados de Enterobacterales de carnes de animais para consumo

Uso da ferramenta de metagenômica na detecção de patógenos de importância clínica produtores de ESβL e carbapenemases em diferentes hospedeiros
Rastreando a evolução de MRSA visando descobrir importantes biomarcadores para caracterizar rapidamente clones específicos de MRSA envolvidos em infecções hospitalares na corrente sanguínea

Ciência de dados na tuberculose resistente a drogas no Brasil

Aplicação de tratamento de oxidação solar sustentável e de baixo custo para a prevenção da resistência microbiana em efluentes no Brasil

Inativação de plasmídeos por uma cevada etíope: Uma abordagem natural de alimentação para reduzir a resistência aos antimicrobianos mediada por plasmídeo
Últimos estudos publicados em Resistência Antimicrobiana
- Human pandemic K27-ST392 CTX-M-15 extended-spectrum β-lactamase-positive Klebsiella pneumoniae: A one health clone threatening companion animals - 12/2022
- Challenges on solar oxidation as post-treatment of municipal wastewater from UASB systems: Treatment efficiency, disinfection and toxicity - 12/2022
- Exploring the Bacteriome and Resistome of Humans and Food-Producing Animals in Brazil - 08/2022
- World Health Organization critical priority Escherichia coli clone ST648 in magnificent frigatebird (Fregata magnificens) of an uninhabited insular environment - 08/2022
- Solar photo-Fenton mediated by alternative oxidants for MWWTP effluent quality improvement: Impact on microbial community, priority pathogens and removal of antibiotic-resistant genes - 08/2022
- Different Swine Production Systems Can Shape Slurry Resistome at Mechanism and Class Levels Based on Swine Manure Evaluation - 07/2022
- Large Scale Genome-Centric Metagenomic Data from the Gut Microbiome of Food-Producing Animals and Humans - 06/2022
- Genomic Analysis of a Highly Virulent NDM-1-Producing Escherichia coli ST162 Infecting a Pygmy Sperm Whale (Kogia breviceps) in South America - 06/2022
- Genomic insights of high-risk clones of ESBL-producing Escherichia coli isolated from community infections and commercial meat in southern Brazil - 06/2022
- Genomic insights of high-risk clones of ESBL-producing Escherichia coli isolated from community infections and commercial meat in southern Brazil - 06/2022
- Phylogenomic analysis of CTX-M-15–producing Enterobacter hormaechei belonging to the high-risk ST78 from animal infection: another successful One Health clone? - 06/2022
- Susceptibility to first choice antimicrobial treatment for urinary tract infections to Escherichia coli isolates from women urine samples in community South Brazil - 06/2022
- High-Frequency Detection of fosA3 and blaCTX–M–55 Genes in Escherichia coli From Longitudinal Monitoring in Broiler Chicken Farms - 05/2022


